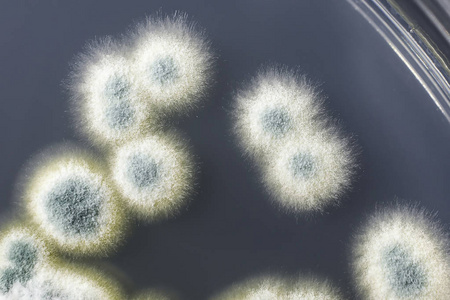
青霉菌菌落在沙氏葡萄糖琼脂上的研究

青霉菌图画

青霉菌简笔画
图片尺寸500x444
青霉菌简笔画
图片尺寸500x410
学生绘画作品系列之青霉的结构(人教版初中生物八年级上册细菌和真菌)
图片尺寸1728x1080
青霉菌简笔画
图片尺寸500x319
青霉菌简笔画
图片尺寸268x317
瓦克青霉(菌种)
图片尺寸597x448
如图是青霉的结构图,请完成填空.
图片尺寸212x198
青霉菌简笔画
图片尺寸212x300
酒色青霉菌种
图片尺寸700x500
青霉的菌体有什么构成,属于什么细胞霉菌,是什么核生物
图片尺寸347x311543真菌观察青霉和酵母菌
图片尺寸1080x1439青霉菌图片_百度百科
图片尺寸378x500青霉菌的显微照片
图片尺寸1100x1100青霉菌,建筑结构,生物学,菌丝,微生物学
图片尺寸1100x1160
青霉菌的故事
图片尺寸600x577
显微镜霉菌简笔画
图片尺寸347x500
发霉的面包和关-在上面看法关于青霉菌真菌,指已提到的人引起照片
图片尺寸450x300
青霉菌结构图简笔画
图片尺寸1318x500白色背景,菌丝,青霉菌,孢子,分生孢子
图片尺寸1200x714
青霉菌菌落在沙氏葡萄糖琼脂上的研究
图片尺寸450x300